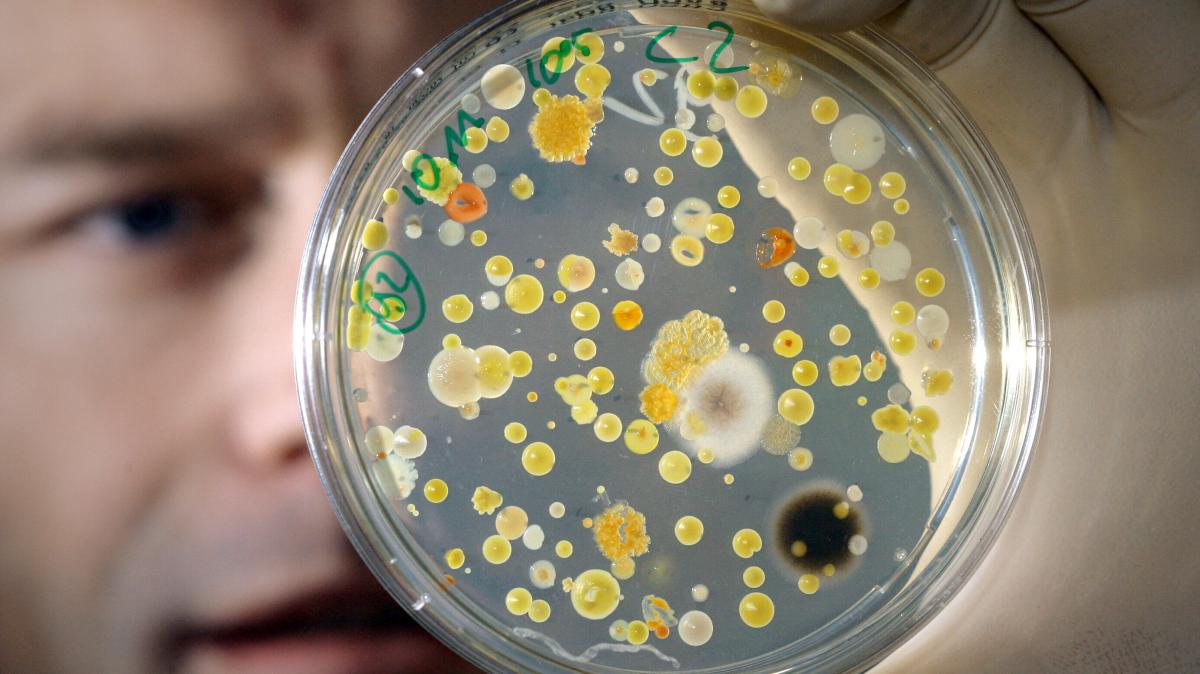

Moscow Weekend at Bemont
On April 18, 2026, a quiet Instagram post from @kalashhik—showing a weekend stroll through Moscow’s Bemont district—became an unexpected lens into Russia’s evolving social fabric, revealing how urban leisure patterns ... Read More